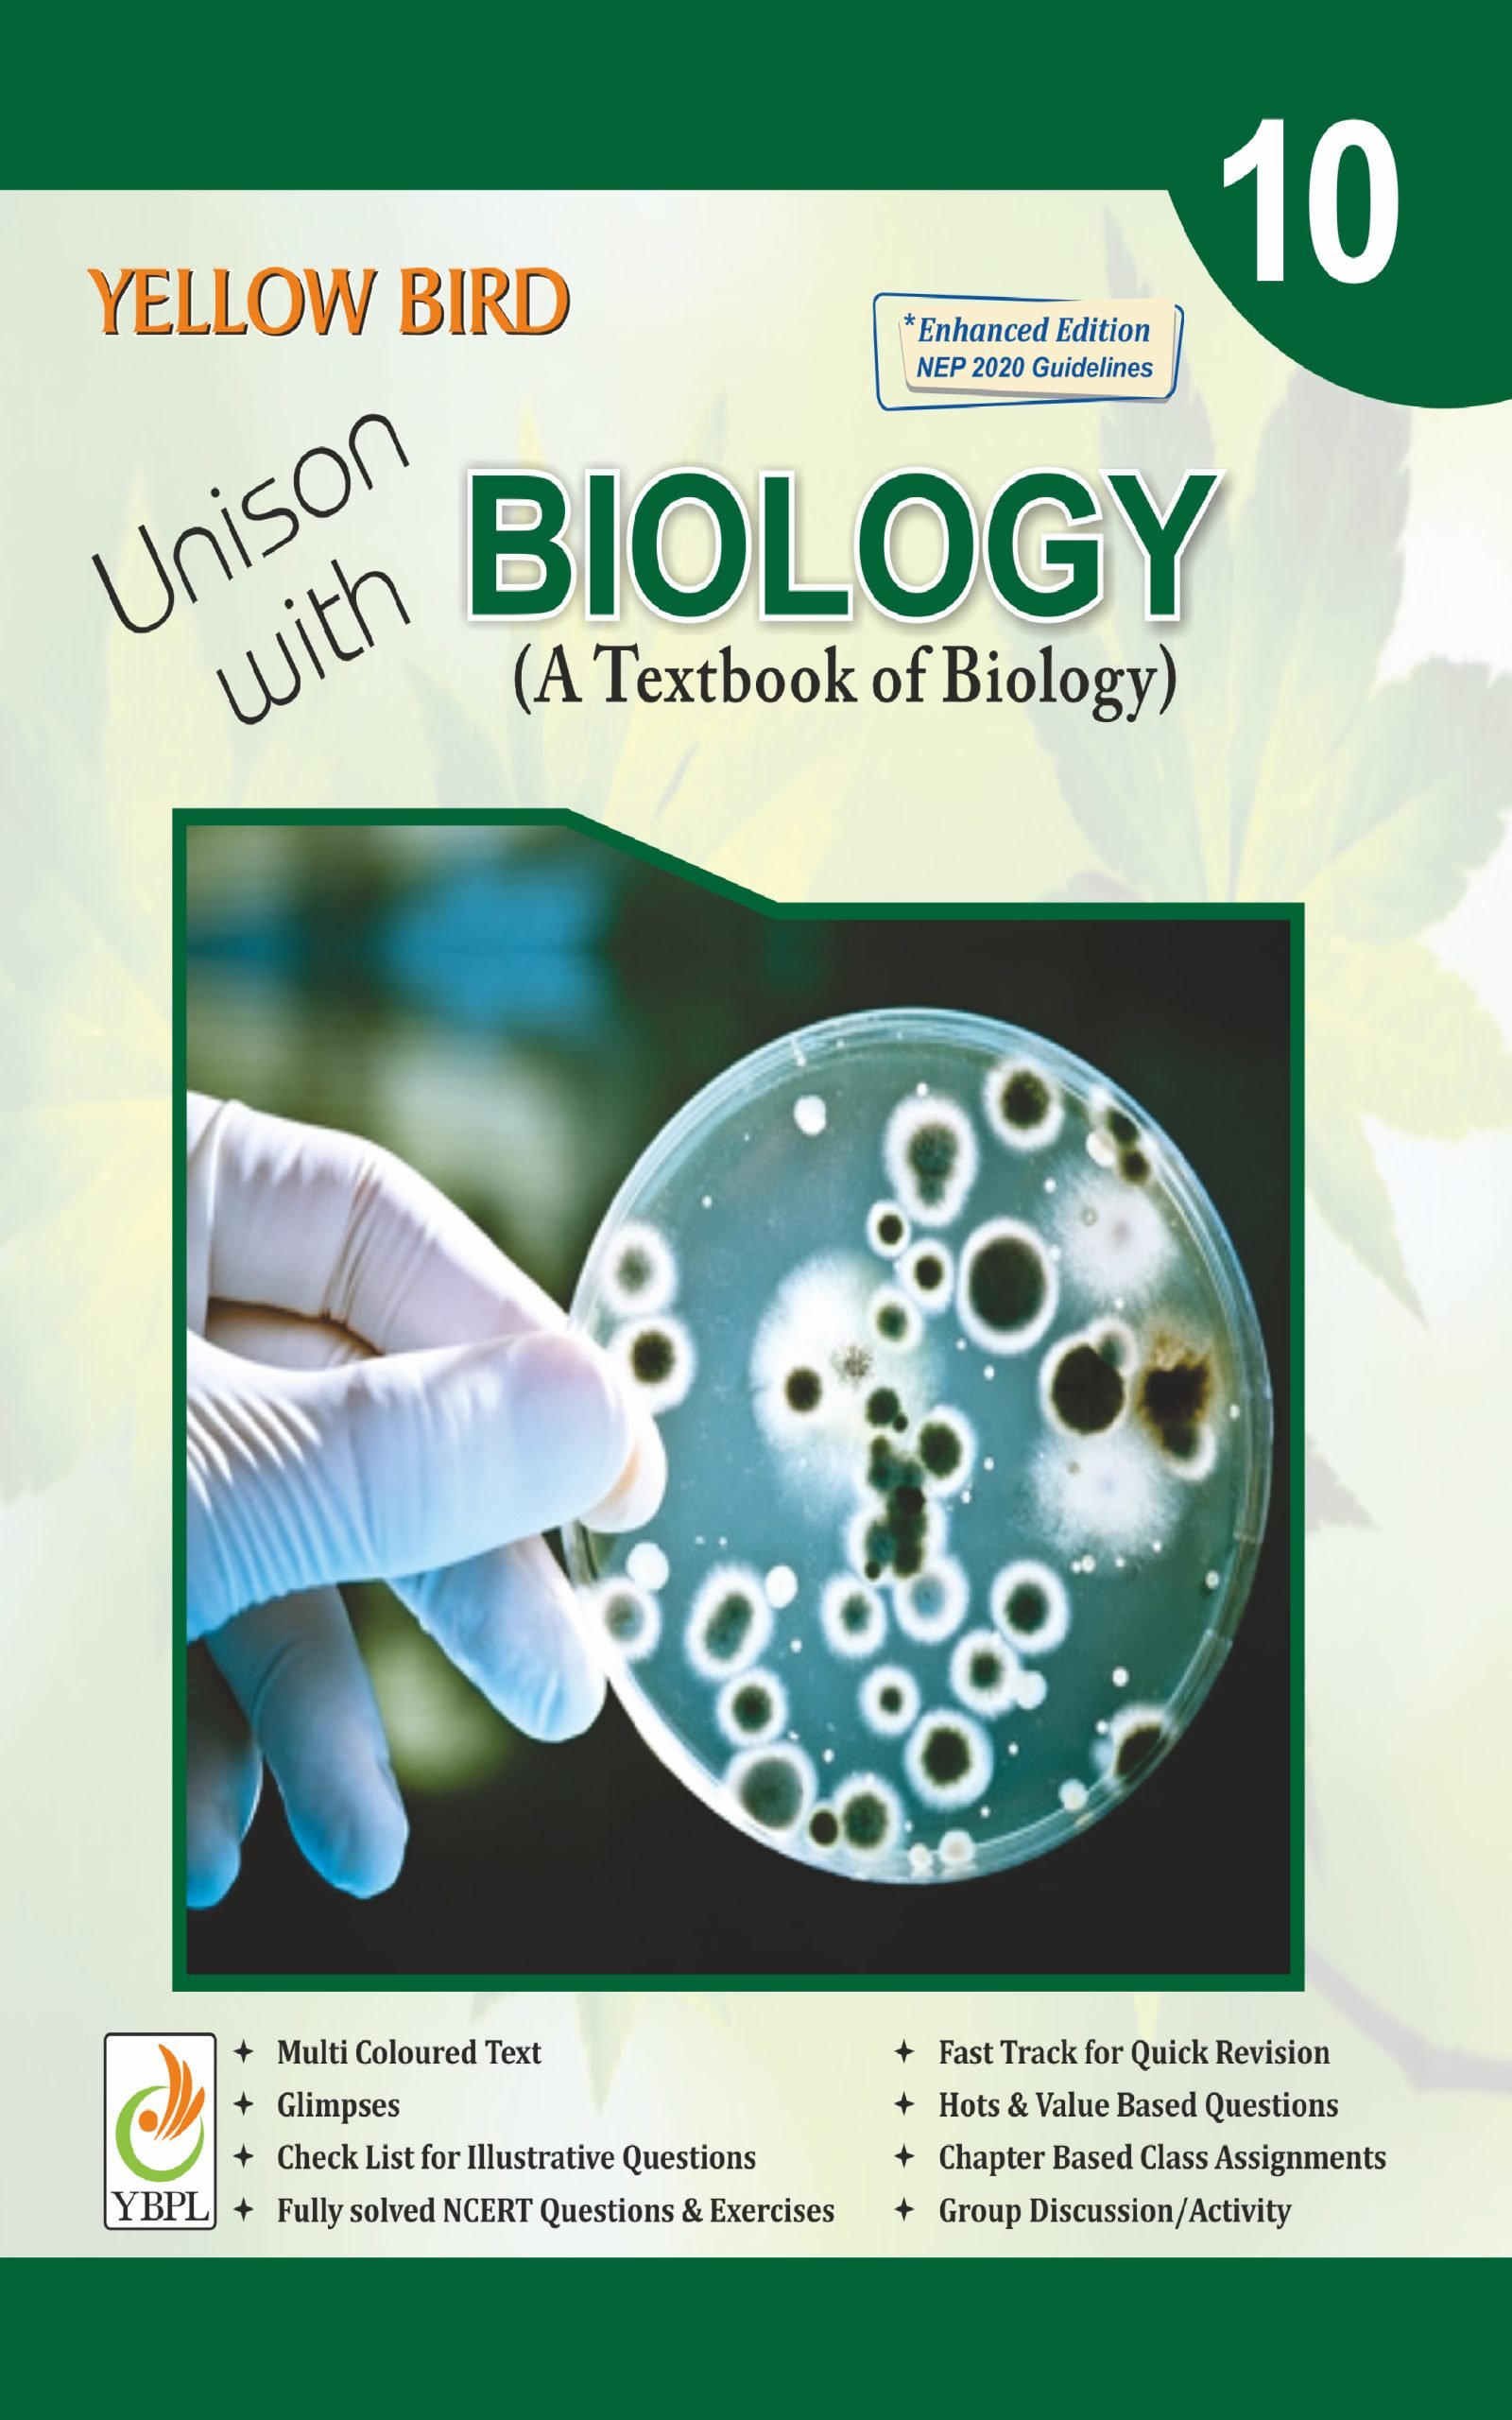

Exploring the Wonders: CBSE Biology Lab Manual Class 12
Introduction Education is an exciting voyage of discovery; and when it comes to biology, hands-on experiences are absolutely crucial. Recognizing this fact, Central Board of Secondary Education (CBSE) recognizes its significance by publishing “CBSE Biology Lab Manual Class 12.” This manual serves as an indispensable guide in unlocking life’s mysteries through experiments, observations and analyses. … Read more